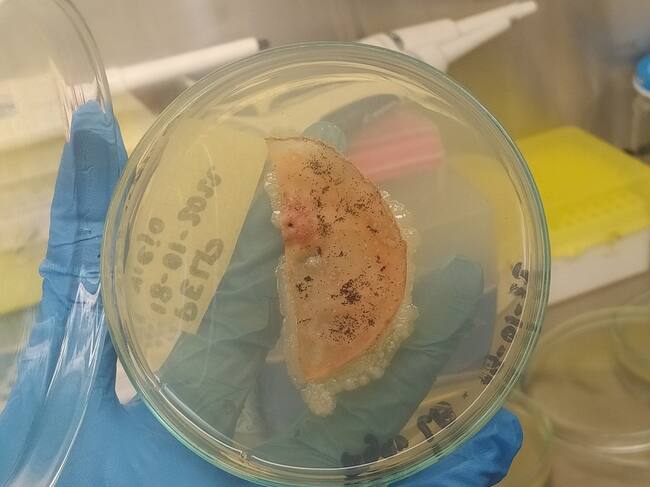

Bacterias de la Antártida podrían ayudar a eliminar residuos plásticos
Así lo determinó una investigación científica realizada por Diana Carolina Rubiano, profesora de la de la Universidad Tecnológica de Bolívar
Universidad Tecnológica de Bolívar

Cartagena
Una investigación científica realizada por Diana Carolina Rubiano, profesora de la Facultad de Ciencias Básicas de la Universidad Tecnológica de Bolívar (UTB), permitió determinar el potencial de bacterias que viven por debajo de los 5°C provenientes de sedimentos marinos de la Antártida, para la degradación del PET (Tereftalato de Polietileno), un tipo de plástico usado en envases de bebidas y textiles.
El estudio permitió el aislamiento y caracterización de ocho cepas bacterianas capaces de crecer usando como única fuente de carbono PET. La evaluación de degradación del material indicó pérdida de peso de hasta 7%, afectación de la estructura química del polímero y evidencia de cambios físicos en las películas en forma de grietas y agujeros.
Sin duda, los resultados de esta investigación permiten avanzar en el desarrollo de una solución para combatir la contaminación por este tipo de material a nivel nacional y global. Esto, teniendo en cuenta que de acuerdo con la experta “el uso de plásticos en Colombia cada vez tiene una mayor demanda debido a su aporte en el mejoramiento en la calidad de vida de los ciudadanos, ya que estos materiales son usados en áreas como medicina, industria de alimentos, agricultura, entre otros”.
Adicionalmente, según el Ministerio de Ambiente y Desarrollo Sostenible, se estima que cada persona genera 2 kg de desechos plásticos al mes y esto deja un producto total de 12 millones de toneladas al año, ya que Colombia cuenta con más de 50 millones de habitantes.
“En Colombia el conocimiento sobre la contaminación por plásticos es limitado. Se estima que aproximadamente el 65% de los residuos sólidos generados en las poblaciones costeras son eliminados en vertederos a cielo abierto o en cuerpos de agua natural. Por lo tanto, estos hallazgos pueden contribuir al desarrollo de alternativas amigables con el medio ambiente para eliminar los residuos de este material presentes en diferentes matrices ambientales”, explica Rubiano.
Rubiano también explica que: “Estas bacterias presentan una gran importancia económica y biotecnológica, ya que su uso en biorremediación puede contribuir a la implementación de estrategias alternativas para el tratamiento de este tipo de residuos que permitan controlar y mitigar el impacto ambiental ocasionado por el plástico”.
En este sentido, el aislamiento y la caracterización de bacterias degradadoras de PET de sedimentos antárticos, representa un aporte a la generación de nuevo conocimiento sobre el potencial de microorganismos que viven en condiciones extremas para degradar polímeros derivados del petróleo y para la biorremediación de ambientes contaminados con plástico.




